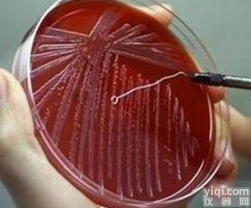
<em>改良</em>EC<em>肉汤</em>（mEC+n）基础 <em>改良</em>EC<em>肉汤</em>（mEC+n）基础价格

改良卵磷脂肉汤低价促销
- 产地:中国大陆
- 供应商:上海江莱生物科技有限公司
- 供应商报价:1
- 标签:改良卵磷脂肉汤低价促销,生物试剂,生化试剂,供应改良卵磷脂肉汤低价促销,上海江莱生物科技有限公司
改良卵磷脂肉汤低价促销 使用方法:
1、沿铝塑袋侧边缺口处撕开或用剪刀剪开封口,取出产气包。
2、将产气包立即放入装有培养皿的2.5L厌氧培养袋中,并密封培养袋。此时产气包将会吸收培养袋内的O2 ,并同时产生CO2。
3、一般情况下,在60分钟内,氧气被完全吸收,同时产生约20~21%的二氧化碳。
注意事项:
1、本产品置于室温(15-25℃)干燥条件下可保存12个月,更长时间的保存可置于2-8℃。
2、如果试剂盒中的溶液出现沉淀,可在65℃水浴中重新溶解后再使用,不影响效果。
3、样品应避免反复冻融,否则会导提取量也下降。
4、产品超过保质期,结块或颜色变化都不能使用。
改良卵磷脂肉汤低价促销 按照培养基用途分培养基按其特殊用途可分为加富培养基、选择性培养基和鉴别培养基。
(1)加富培养基。是在培养基中加入血、血清、动植物组织提取液,用以培养要求比较苛刻的某些微生物。
(2)选择性培养基。是根据某一种或某一类微生物的特殊营养要求或对一些物理、化学抗性而设计的培养基。利用这种培养基可以将所需要的微生物从混杂的微生物中分离出来。
(3)鉴别培养基。是在培养基中加入某种试剂或化学药品,使培养后会发生某种变化,从而区别不同类型的微生物。
【改良卵磷脂肉汤低价促销】厂家特价现货供应中,价格优惠,质量可靠。公司提供产品储存条件、用途、注意事项及完善的售后服务,欢迎您的来电订购!部分产品信息:
【英文名称】欢迎来电咨询. 【编号】27012 【规格】250g 【包装用途】可参考产品说明书(欢迎来电索取产品说明书)
本公司所有产品包括【改良卵磷脂肉汤低价促销】等仅用于科研,不得用于临床,详细信息请联系我司销售客服,同时欢迎您询价或索取说明书,询价留言表(↓↓↓)、电话、在线客服QQ、发送电子邮件均可,江莱生物是专业的高品质科研试剂供应商,请您放心购买!其他相关产品:
CAS:6368-72-5,苏丹红7B,溶剂红19,脂肪红7B,Sudan red 7B 小鼠可溶性核因子κB受体活化因子配基(sRANKL)ELISA检测试剂盒说明书 盐酸羟嗪标准品/对照品 bs-11359R,神经元突触膜胞外分泌调节蛋白3抗体|RIMS3抗体价格 敌稗标准品|对照品,cas:709-98-8 bs-11821R,二氢嘧啶酶相关蛋白3抗体|CRMP3抗体价格 植物腺苷二磷酸葡萄糖焦磷酸化酶(AGP)ELISA检测试剂盒说明书 猪组织型纤溶酶原激活剂(t-PA)elisa试剂盒,96T/48T 阳离子黑 ON有现货 bs-4006R,芳基硫酸酯酶A抗体|ARSA抗体价格 人甲胺喋呤(MTX)ELISA试剂盒,96T/48T 去甲升麻精标准品,cas:49624-66-0对照品 犬瘟热(CDV)ELISA检测试剂盒说明书 出血性大肠杆菌(EHEC)核酸检测试剂盒(PCR-荧光探针法) CAS:57149-07-2,萘哌地尔现货供应 bs-8710R,视觉YZ蛋白抗体|Visual Arrestin抗体价格 CAS:873-83-6,6-氨基尿嘧啶价格 重组人 PCBP1 蛋白(His 标签)/11628-H07E bs-7866R,精子顶端体蛋白10抗体|Intra Acrosomal Protein抗体价格 人杀菌肽(cecropin)ELISA检测试剂盒说明书 木鳖子对照品/标准品 重组人 OXSR1/OSR1 蛋白(GST 标签)/10727-H09B bs-2552R,干扰素诱导T细胞趋化因子抗体|CXCL11抗体价格 毛兰素对照品/标准品 bs-1845R,LRIG2抗体|LRIG2抗体价格 CAS:52435-14-0,阳离子嫩黄7GL有现货 bs-6457R,胰岛素样生长因子1受体β/IGF-IRβ 抗体|IGF-I Receptor beta抗体价格 人丁型肝炎IgM(HDVIgM)ELISA检测试剂盒说明书 bs-10301R,A型H7N9 M1蛋白抗体|H7N9 HA抗体价格 人肿瘤坏死因子相关凋亡诱导配体3(TRAIL-R3)ELISA试剂盒,96T/48T bs-11389R,含丙氨酰tRNA合成酶结构域1抗体|AARSD1抗体价格 bs-7693R,肾胺酶抗体|Renalase抗体价格 间甲酚标准品/对照品 人糖化血红蛋白,HbA1c抗体 CAS:434-03-7,炔孕酮现货供应 bs-3027R,磷酸化腺苷单磷酸活化蛋白激酶β1抗体|phospho-AMPK beta 1 (Ser182)抗体价格 CAS:105635-65-2,分散蓝 S-3G有现货 重组小鼠 MOG(aa30-149) 蛋白(His 标签)/51046-M08E CAS:629-94-7,二十一烷Heneicosane价格 棉纤维素标准品,cas:652-78-8对照品 白桦脂酸标准品,cas:472-15-1对照品 CAS:5534-95-2,五肽胃泌素现货供应 络石藤标准品/对照品 bs-0308R-Cy7,Cy7标记的兔抗马IgG|Rabbit Anti-horse IgG/Cy7抗体价格 CAS:5721-91-5,葵酸睾酮现货供应